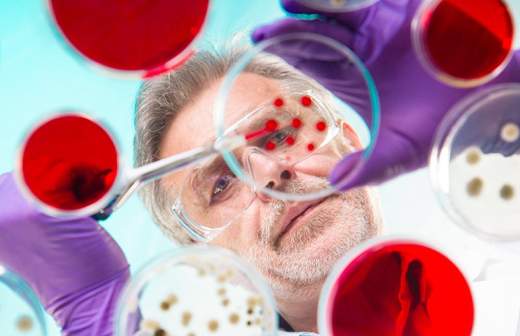

Человек-конструктор

Современные медицинские технологии позволяют устанавливать бионические протезы, трансплантировать руки, редактировать мутировавшие гены не только человека, но даже яйцеклетки перед оплодотворением. Смогут ли врачи когда-нибудь полностью избавить нас от болезней? Нужно ли человеку орлиное зрение? Почему легче вылечить генетические болезни, чем гипертонию? Будем ли мы через 20 лет выбирать пол будущего ребенка? Что ученым удалось сделать для лечения болезни Паркинсона и как одна инъекция избавит от гемофилии? Об этом «Известия» поговорили на круглом столе с ведущими российскими специалистами в области генетики, трансплантологии, офтальмологии и клеточной биологии.
Нюх, как у собаки, глаз, как у орла
«Известия»: Некоторые функции человека по сравнению с животными можно считать ограниченными: у нас не такое острое зрение, слух. Будет ли наука двигаться в сторону совершенствования индивида?
Христо Тахчиди, проректор по лечебной работе Российского национального исследовательского медицинского университета им. Н.И. Пирогова Минздрава РФ, директор НИЦ офтальмологии РНИМУ, доктор медицинских наук, член-корреспондент РАН: Наши технологии первобытны в сравнении с уникальной конструкцией, созданной природой. Мы можем искусственно сделать зрение остротой в две единицы, но при этом потеряем ряд других функций. Например, сумеречное зрение, контрастность, различение цветов, стереоскопическое, глубинное зрение. Каждая добавка к природной универсальности отнимает предельные функции в отдельном направлении.

Сергей Готье, главный трансплантолог Минздрава РФ, директор Национального медицинского исследовательского центра трансплантологии и искусственных органов им. В.И. Шумакова, завкафедрой трансплантологии и искусственных органов Первого МГМУ им. И.М. Сеченова, заслуженный врач РФ, академик РАН, доктор медицинских наук, профессор: Я не думаю, что мы должны идти по линии совершенствования организма в одном направлении в ущерб другим. У меня был случай: у врача, который занимался хирургией пищевода, не было мизинца. Он говорил: «Я бы еще один палец себе удалил. Мне удобно делать манипуляцию около шеи, заходя с диафрагмы». Но утраченные функции социально ущемляют людей, развивая их в одну сторону.
Сергей Куцев, главный специалист по медицинской генетике Минздрава РФ, директор Медико-генетического научного центра, член-корреспондент РАН, доктор медицинских наук, профессор: Я не считаю, что улучшение генома будет перспективным. Сейчас модно рассуждать, почему бы, используя современные технологии экстракорпорального оплодотворения и возможности редактирования генома, не обеспечить спортивные успехи будущего человека? Но нет одного или нескольких генов, которые предопределяют достижение спортивных успехов. Наука может доказать, что какая-то аллель встречается чаще у спортсменов, чем у обычных людей. Но развивая эту аллель, мы можем получить такую же предрасположенность к какому-либо заболеванию.
Улучшение человеческой породы неприемлемо. Другое дело — вмешательство в патологический процесс.
Мария Лагарькова, руководитель лаборатории клеточной биологии Федерального научно-клинического центра физико-химической медицины ФМБА России, член-корреспондент РАН, доктор биологических наук: То, что мы такие генетически разные, помогло нам и помогает до сих пор выживать как виду. Именно в нашем разнообразии наша сила как человечества. Минорные отличия друг от друга позволили в свое время людям широко распространиться в достаточно тяжелых климатических условиях.
Сергей Готье: Лучше сохранить и развивать то, что есть, чем выдумывать что-то новое и потом не знать, куда это деть. Международной трансплантологии свойственно кидаться в разные стороны, отходя от рутинных, совершенно необходимых методов трансплантации, круг которых ограничен: это пересадка почки, печени, сердца и легких. Это четыре органа, без которых человек жить не может. Всё остальное можно не пересаживать.
«Известия»: Тем не менее пересаживают даже конечности. Оправдано ли это?
Сергей Готье: В мире были случаи, когда человеку с ампутированными конечностями пересаживали одну или две руки. Но пересадка конечности требует очень высокой иммуносупрессии, а она влечет риск вирусной инфекции и онкологических заболеваний. Поэтому бионический протез гораздо перспективнее и менее вреден для пациента.
«Известия»: У пациента с бионическим глазом не было побочных эффектов, которые бывают при трансплантации?
Христо Тахчиди: С точки зрения переносимости продуктов искусственный материал более управляем, чем биологический. Искусственные материалы более инертны и пластичны. Вопрос к биологам и технарям, как заставить их функционировать.
У бионического направления есть своя ниша, но гораздо интереснее — суметь проникнуть в микромир и лечить на уровне клеток.
Сергей Куцев: Наши молекулярные технологии никогда не заменят трансплантацию или бионические протезы. Всегда будут травмы. Есть области, где молекулярные технологии не смогут быть полезными в ближайшие десятилетия. Мы пока не в состоянии излечить пациента от артериальной гипертензии или бронхиальной астмы.
«Известия»: Получается, что генетические болезни проще вылечить?
Сергей Куцев: В ближайшем будущем — да. Вся группа заболеваний, которые не затрагивают ментальности ребенка, очень перспективна для излечения. Например, гемофилия или наследственный иммунодефицит. Но есть наследственные заболевания, которые развиваются еще внутриутробно. Диагноз не сразу можно поставить, происходит задержка психомоторного развития. Здесь помочь очень сложно, потому что речь идет о головном мозге.
«Известия»: А внутриутробно их когда-нибудь можно будет лечить?
Сергей Куцев: Теоретически — да.
Мария Лагарькова: Когда мы планируем заниматься евгеникой, надо быть в три, в четыре раза осторожнее. Известный эмбриолог Шухрат Миталипов показал возможность редактирования генома на уровне яйцеклетки. Диагностировать потенциальные наследственные заболевания можно на стадии нескольких клеток. Но отдаленные последствия редактирования генома мы пока не видели.

У редактирования генома есть потенциальный off-target effect, когда редактируется не только в месте, в котором нужно, но по разным причинам еще в каких-то местах. Это проблема, которая до сих пор не решена полностью даже на уровне лабораторных экспериментов.
Кроме того, редактирование будущего человека — это вопрос этики.
Сергей Куцев: Каждый из нас является носителем мутантных аллелей, которые могут быть причиной наследственного заболевания. Риск появления детей с врожденной наследственной патологией — 5%. Говорить об ЭКО и преимплантационной диагностике мы должны тогда, когда в семье есть тот или иной случай наследственного заболевания. В качестве общепопуляционных такие технологии неприменимы.
«Известия»: А если придет человек с большими деньгами и скажет: «Сделайте мне ребенка с голубыми глазами, блондина»?
Сергей Куцев: Были примеры, когда семья принимает решение о прерывании беременности из-за неподходящего пола ребенка. Это, мягко говоря, неэтично и антинаучно, потому что мы влезаем в соотношение полов, которое устанавливается естественными закономерностями.
Христо Тахчиди: Человек — существо достаточно пластичное, поэтому не надо ничему удивляться. С другой стороны, всё это дает прогресс. Когда люди начинают заниматься подобными вещами и ищут, как их разрешить, появляется колоссальный естественный опыт. Гинеколог Роберт Эдвардс взял на себя ответственность и осуществил первое экстракорпоральное оплодотворение. Он рискнул, какая-то женщина на это согласилась. И человечество выиграло от этого. Множество семей наконец получило потомство.
Работа над ошибками
«Известия»: Вы выразили единодушное мнение, что вмешиваться в организм человека стоит только с целью восстановления его функций. Что мы уже умеем или скоро сможем делать с генетической точки зрения?
Мария Лагарькова: Мы уже можем исправить точечную мутацию in vitro — на модельных организмах, в чашке Петри и даже на экспериментальных моделях эмбриона человека.
Мы можем так репрограммировать взрослую клетку кожи, что она становится эмбриональной клеткой, а потом, например, нейроном, пигментным эпителием сетчатки, мышцей. С репрограммированными клетками идут клинические испытания в Японии и начинаются в других странах. Сейчас до клинических испытаний дошли искусственно созданные дофаминергические нейроны. Они позволят лечить болезнь Паркинсона.
Сергей Куцев: Генетики и клеточные биологи работают вместе. Есть подход, когда от конкретного пациента можно получить фибробласты, перепрограммировать их в стволовые клетки, провести редактирование генома, затем эти клетки трансплантировать обратно, чтобы они прижились в организме и стали выполнять функцию, которая была утрачена в связи с мутацией определенного гена. Здесь сочетаются клеточные и генетические технологии.

Есть подходы, которые уже вышли из лаборатории и находятся на разных фазах клинических исследований. Мы используем вирусные векторы — систему доставки, к которой присоединены системы редактирования генома. Уже проведены клинические испытания для лечения одного из мукополисахаридозов — тяжелого наследственного заболевания, которое сопровождается поражением сердечно-сосудистой, костной системы, центральной нервной системы. В третьей фазе клинических испытаний (это уже перед выходом в практику) препарат для лечения гемофилии А, разработанный на основе технологий редактирования генома. Одна инъекция — и полное выздоровление. Это зарубежная разработка.
«Известия»: Отредактировать геном можно будет и взрослому человеку, и ребенку?
Сергей Куцев: Конечно. Технология редактирования генома будет эффективнее, чем генная терапия. Она универсальна для лечения наследственных заболеваний, которых несколько тысяч. У нас, к сожалению, пока идут лишь единичные разработки.
«Известия»: Возможности трансплантологии ограничены тем, что не хватает донорских органов. Что можно вырастить для пересадки с помощью клеточных технологий?
Сергей Готье: Если иметь в виду возможности молекулярной, генной терапии, они в значительной степени снимут с нас бремя создания методики выращивания чего-то. Наше научно-экспериментальное направление очень серьезное — мы работаем в области регенеративной медицины. Это композиция матрикса с клеточной культурой. Мы можем сейчас сделать ткань печени и хряща. Но с этим тоже нужно быть очень осторожным. Это рост клетки, регенерация.

«Известия»: Может вызвать онкологические заболевания?
Сергей Готье: Никто этого исключить не может. Мы сильно ограничены в клинических наблюдениях — их просто нет. Не можем сказать, что будет с этой тканью через год при воздействии всех факторов окружающей среды, лекарственной терапии.
«Известия»: Насколько перспективна ксенотрансплантация (межвидовая трансплантация)?
Сергей Готье: Экспериментальное животное может быть использовано в качестве биореактора для выращивания другого органа или ткани. Но проблема — в передаче зоологических вирусов. Человечество давно бьется над этим и справиться пока не может. По конвенции ВОЗ, которой следует и Российская Федерация, ксенотрансплантацию нельзя применять к человеку.
«Известия»: В мире это делается?
Мария Лагарькова: Есть совершенно потрясающая работа Хиромицу Накаучи — японского исследователя, который сейчас работает в Стэнфорде. Используя технологии эмбриологии, Накаучи вырастил сначала в крысе мышиную поджелудочную железу, потом крысиную в мутантном поросенке. Было интересно, какого размера получатся органы. Оказалось, что размер определяется реципиентом. В крысе мышиное будет крысиного размера. Если крысиную железу вырастить в мыши, она будет мышиного размера. Сейчас Накаучи пытается получить разрешение на выращивание поджелудочной железы человека в организме животного.
Сергей Куцев: В бактериях и других микроорганизмах есть системы, которые редактируют геном. Эту технологию не изобрел человек, она существует в природе для того, чтобы исправлять случайные дефекты. Поиском новых таких систем активно занимаются наши ученые.
Здоровье — по-научному
«Известия»: Можно предположить, что лет через 20–30 мы сможем так редактировать геном, что все люди будут рождаться здоровыми?
Сергей Куцев: Есть мутации de novo, которые возникают в половой клетке одного из родителей. Предугадать их возникновение достаточно сложно.
«Известия»: Давайте пофантазируем, что мы через 20 лет уже будем уметь.
Сергей Куцев: Начнем с реальности. У нас есть возможность лечить более 300 наследственных заболеваний, чего еще 20 лет назад и предположить не могли. Есть ферментозаместительные препараты. Такие подходы используются для лечения фенилкетонурии. Есть заболевание — дефицит липазы липопротеинов, для которого был создан и разрешен к использованию FDA и EMA генотерапевтический препарат, являющийся комплексом вирусного вектора и нормального гена. Мы всё время увеличиваем перечень, который можем использовать для лечения наследственных заболеваний, поэтому через 20 лет я вижу достаточно хорошие перспективы. Останется профилактика на преимплантационном уровне, на пренатальном уровне.
Христо Тахчиди: Через 20 лет мы не победим все болезни. Но движение вперед будет по всем направлениям: и в генетике, и в бионических системах, и в трансплантологии.
Редактирование генома — гигантская область, в которую мы только вошли. Мы получили пока два-три инструмента, научились ими манипулировать, а о том, что из этого выйдет, получаем лишь первые крупицы знаний. Мы только в начале пути изучения. Потребуется гораздо больше 20 лет.
«Известия»: На каком уровне находится трансплантология? Что изменит закон, который сейчас рассматривает правительство?
Сергей Готье: В технологии он ничего не изменит. До недавнего времени трансплантация в стране развивалась вопреки имеющимся условиям — организационным, экономическим и психологическим. Вообще не было системной работы по объяснению населению необходимости донорства органов.
За рубежом есть регистры отказов от посмертного донорства, куда может записаться любой совершеннолетний гражданин. В остальных случаях наступает презумпция согласия. У нас базы прижизненного волеизъявления пока нет. Мы ждем от нового закона ее появления.
«Известия»: Как вы работаете в отсутствие нового закона?
Сергей Готье: Мы делаем всё возможное, чтобы помочь большему числу больных. В этом отношении хорошая ситуация по организации донорства сложилась в Москве. За прошлый год у нас в центре сделана 161 трансплантация сердца, чего в мире в одном учреждении не делает никто. Вчера мы пересадили 115-е сердце с начала года. Темп нарастает.
«Известия»: Будущее медицины — это некий синтез биологии, генетики и инженерии?
Христо Тахчиди: Безусловно. Электроники, клеточных технологий. Это интегрированная система.
«Известия»: Какой будет медицина через 20 лет?
Сергей Готье: Останется бесплатной.
Сергей Куцев: Внешне мало что изменится. Всё равно будет необходим визит к врачу, забор биологических проб, инструментальные обследования. Только мы будем получать информацию другого уровня. Думаю, что через 20 лет у нас будет гораздо больше биологических маркеров, по которым мы сможем на ранних стадиях выявить или заподозрить заболевания. Болеть человечество будет и через 20, и через 100 лет. Но технологии будут совершенствоваться, и поэтому увеличится продолжительность жизни.
Мария Лагарькова: Кроме развития диагностики и предиктивной медицины должна развиваться реабилитация. Будут совершенствоваться подходы к восстановлению человека после болезни. И, конечно, улучшится профилактика. Эти два компонента приводят к полноценному долголетию.
Христо Тахчиди: У нас мощно развивается направление дистанционной диагностики. Айфоном можно снять глазное дно и переслать врачам на осмотр. Через 20 лет эти методы станут рядовым явлением. И это очень важно, потому что проблема ранней диагностики в основном упирается в нежелание посещать поликлинику. Дистанционное обследование через домашний компьютер сделает ее быстрой, своевременной и эффективной.